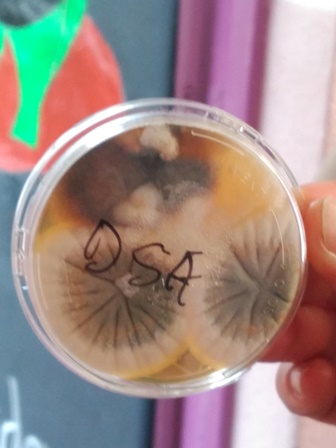
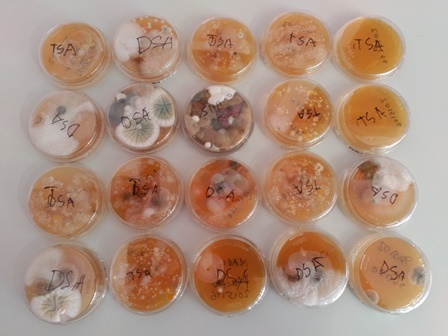

En Miquel, el pare de l’Íker, ens ha vingut a explicar què fa a la seva feina. Hem fet una pràctica amb microorganismes i hem après que estem envoltats de microbis, bactèris, fongs i altres “bichitos”.
Quan hem tocat la gelatina de la preparació dels envasos amb les nostres mans brutes, la sola d’una sabata, una moneda d’euro, la barana de l’escola, hem dipositat milions de microbis. Amb la calor, d’estar dins d’una capsa, s’han desenvolupat perquè han trobat aliment en la gelatina i han pogut reproduir-se. Amb el fred, el seu creixement es fa més lent; per això conservem els aliments a la nevera.
Amb aquest experiment no hem cultivat virus, perquè els virus necessiten un ésser viu per mutiplicar-se.
Els resultats han estat espectaculars. Ara tenim més clar que mai que ens hem de rentar les mans!!!!!!
Moltes gràcies Miquel